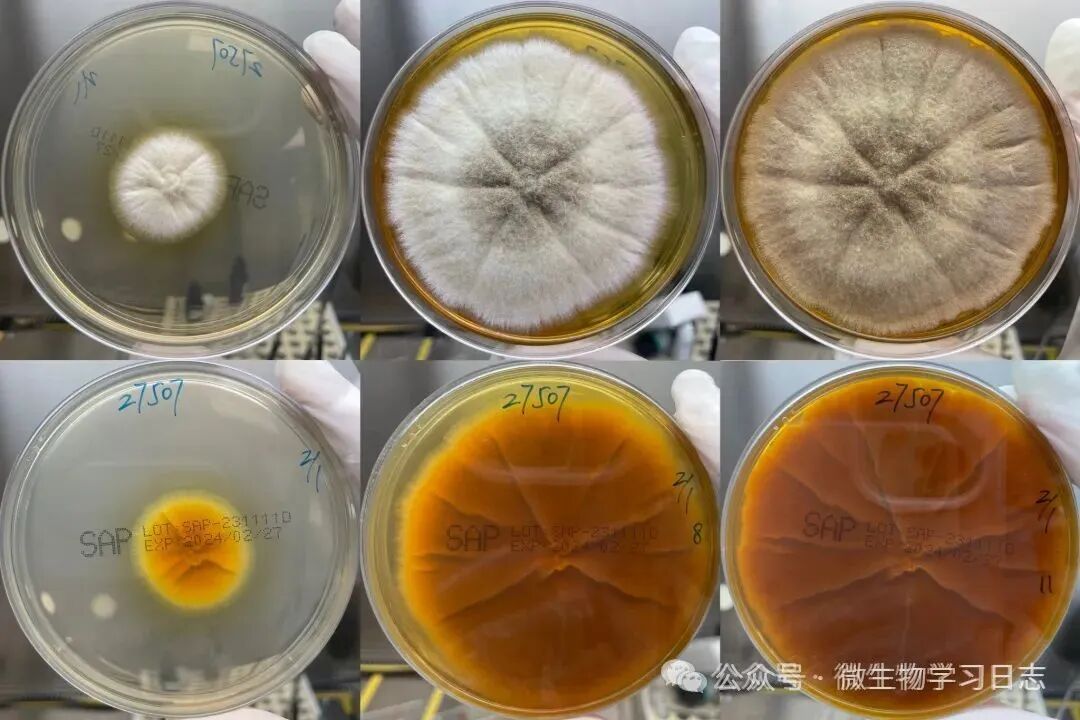

土曲霉(Aspergillus terreus)
土曲霉在環(huán)境中普遍存在,可引起身體多部位感染,甚至可播散性感染;在曲霉屬中唯一具有在體內產生孢子的能力,并對氟康唑和兩性霉素B天然耐藥。
菌落特點
在沙氏瓊脂培養(yǎng)基上通常生長快速,質地呈絨毛狀或粉沫狀,菌落正面為棕色至肉桂色,邊緣白色;反面為黃色至褐色。
圖1 土曲霉在血平板、巧克力平板、麥康凱平板上的菌落形態(tài),圖上排為外耳道膿液35°C培養(yǎng)4天、下排為痰液35°C培養(yǎng)5天?圖2 臨床分離的兩株土曲霉,菌落正面形態(tài)典型,可見放射狀溝紋;菌落反面顏色差別較大,左一列、二列為沙氏瓊脂培養(yǎng)基28°C培養(yǎng)6天、9天;左三列、四列為另外一株菌,沙氏瓊脂培養(yǎng)基28°C培養(yǎng)3天、7天 圖3 沙氏瓊脂培養(yǎng)基28°C培養(yǎng)3天、8天、11天的菌落形態(tài),菌落反面顏色深圖4 沙氏瓊脂培養(yǎng)基28°C培養(yǎng)6天、9天、14天、35天,該菌分離自外耳道膿液,生長較緩慢,菌落形態(tài)從早期的絨毛狀逐漸轉變?yōu)榉勰瓲?/span> 分生孢子頭呈致密柱狀,分生孢子梗光滑,透明,相對較短(100-250μm),微彎曲。頂囊半球形,直徑10-20 μm。瓶梗雙輪,梗基和瓶梗等長,呈致密柱狀,生于頂囊表面2/3處。分生孢子球形或近球形,透明至淡黃色,壁光滑,呈鏈狀排列。當單個的孢子沿著營養(yǎng)菌絲形成時稱為粉孢子。圖5 左一、二為外耳道膿液直接涂片鈣熒光白染色高倍鏡視野(x400),左三為痰涂片革蘭染色油鏡視野(x1000),革蘭染色相對較難著色或染成紫紅色,鏡下較容易漏檢圖6 乳酸酚棉蘭染色,左列圖和右上圖為高倍鏡視野(x400),左上圖可見分生孢子梗短,乍看略有構巢曲霉的錯覺,右上圖和左下圖為原始菌落制片,分生孢子頭“野性”十足;右下圖為油鏡視野(x1000),所見粉孢子個頭通常比分生孢子大,可直接從菌絲側邊冒出,也可帶“柄"掛枝頭。
圖3 沙氏瓊脂培養(yǎng)基28°C培養(yǎng)3天、8天、11天的菌落形態(tài),菌落反面顏色深圖4 沙氏瓊脂培養(yǎng)基28°C培養(yǎng)6天、9天、14天、35天,該菌分離自外耳道膿液,生長較緩慢,菌落形態(tài)從早期的絨毛狀逐漸轉變?yōu)榉勰瓲?/span> 分生孢子頭呈致密柱狀,分生孢子梗光滑,透明,相對較短(100-250μm),微彎曲。頂囊半球形,直徑10-20 μm。瓶梗雙輪,梗基和瓶梗等長,呈致密柱狀,生于頂囊表面2/3處。分生孢子球形或近球形,透明至淡黃色,壁光滑,呈鏈狀排列。當單個的孢子沿著營養(yǎng)菌絲形成時稱為粉孢子。圖5 左一、二為外耳道膿液直接涂片鈣熒光白染色高倍鏡視野(x400),左三為痰涂片革蘭染色油鏡視野(x1000),革蘭染色相對較難著色或染成紫紅色,鏡下較容易漏檢圖6 乳酸酚棉蘭染色,左列圖和右上圖為高倍鏡視野(x400),左上圖可見分生孢子梗短,乍看略有構巢曲霉的錯覺,右上圖和左下圖為原始菌落制片,分生孢子頭“野性”十足;右下圖為油鏡視野(x1000),所見粉孢子個頭通常比分生孢子大,可直接從菌絲側邊冒出,也可帶“柄"掛枝頭。